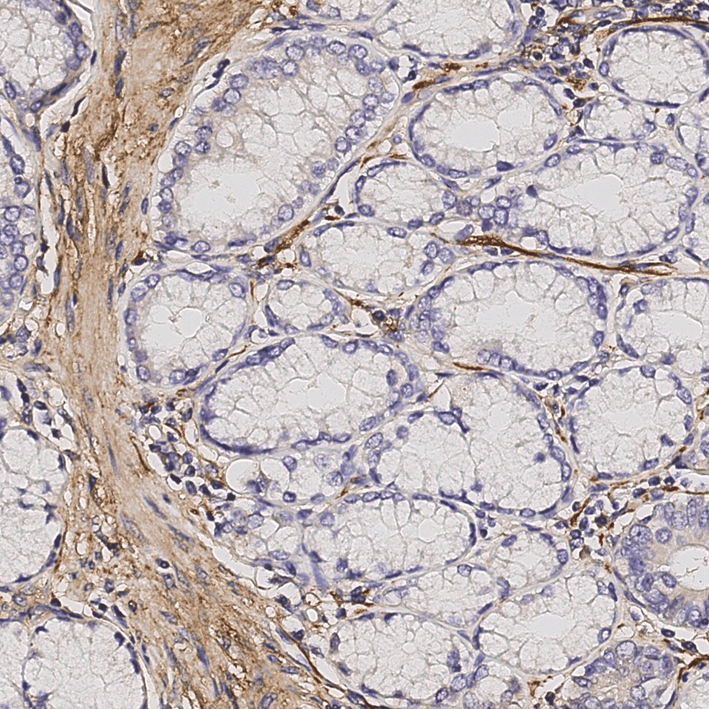

Key Details
About the role
Dr Claus Jorgensen, Group Leader of the Systems Oncology Group, is looking for a Postdoctoral Scientist to join his group. This is a great opportunity for a self-motivated, innovative, meticulous and organised candidate who is keen to work in a dynamic laboratory undertaking cutting edge research.
The goal of the Systems Oncology Group is to understand how the tumour microenvironment, and the desmoplastic reaction, regulates tumour cell function and therapeutic response in pancreatic ductal adenocarcinoma. We have identified a novel target regulating the interactions between tumour cells and the microenvironment, which we believe may be a target for future therapeutic intervention.
The objective of this post is to functionally characterise this target and its role in regulating tumour cells, host cells, and their interactions. Specifically, the post holder will use a number of in vitro cell biology assays to assess cell function and biochemical assays to assess cell signalling in vitro; this will include functional CRISPR analysis, pharmacological studies, enzyme assays and mass spectrometry analysis in 2D and 3D cell models. Tumour models will be analysed by IF/IHC, proteomics, genomics and transcriptionally as well as testing novel combination treatments using available in vivo models (see Hutton et al Cancer Cell 2021, Lee et al Nat Comm 2021 and Below et al Nat Mat 2022). This is a project for a highly collaborative individual seeking to make a difference in a very hard to treat cancer.
About you
You should have a PhD in biochemistry, cell biology or a related field. Experience in protein biochemistry, analysis of cell signalling and use of in vitro models of cancer is required. Experience with in vivo tumour models and immunology is desirable. Key qualities include independent thinking, ability to work in a team and good communication skills, all of which are needed to efficiently work in a multidisciplinary team.
How to apply
To apply for this position please complete the online application via ‘Apply Now’. Please ensure you detail the names of three referees and ensure you submit your application before the closing date specified.
Please note this vacancy will close for applications at 11:59pm on the closing date specified.
Informal enquiries can be directed to Dr Claus Jorgensen via email: claus.jorgensen@cruk.manchester.ac.uk.
Closing date: Sunday 26th October 2025.
1st round interviews: w.c. 10th November 2025.
Contact us for further information
Benefits
Find out how contributions to the Institute are recognised with a generous benefits package
Wellbeing
Our mission is to promote and enhance wellbeing through the development of a proactive and enabling culture.
Equality, Diversity and Inclusion
Read about our commitment to creating an environment where diversity is celebrated and everyone is treated fairly

Personal Development
To enable you to excel in your role and continue to develop, we offer a variety of training and support opportunities
Our Research
Our research spans the whole spectrum of cancer research from cell biology through to translational and clinical studies
Research Groups
Our research groups study many fundamental questions of cancer biology and treatment
Our Facilities
The Institute has outstanding core facilities that offer cutting edge instruments and tailored services from expert staff
Latest News & Updates
Find out all our latest news
Why choose Cancer Research UK Manchester Institute?
The Cancer Research UK Manchester Institute, an Institute of The University of Manchester, is a world-leading centre for excellence in cancer research. The Institute is core funded by Cancer Research UK (www.cancerresearchuk.org),
the largest independent cancer research organisation in the world.
We are partnered with The Christie NHS Foundation Trust, one of the largest cancer treatment centres in Europe, which is located adjacent to the CRUK MI Manchester Institute in South Manchester. These factors combine to provide an exceptional environment in which to pursue basic, translational and clinical research programmes.

Careers that have a lasting impact on cancer research and patient care
We are always on the lookout for talented and motivated people to join us. Whether your background is in biological or chemical sciences, mathematics or finance, computer science or logistics, use the links below to see roles across the Institute in our core facilities, operations teams, research groups, and studentships within our exceptional graduate programme.